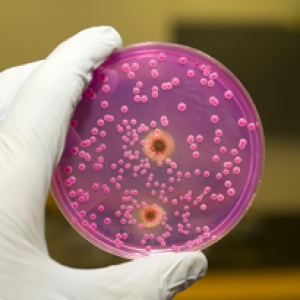

Διαγνωστική βρογχοσκόπηση.. ένα ταξίδι στα μονοπάτια του πνεύμονα
insert-headers-and-footers domain was triggered too early. This is usually an indicator for some code in the plugin or theme running too early. Translations should be loaded at the init action or later. Please see Debugging in WordPress for more information. (This message was added in version 6.7.0.) in /var/www/vhosts/mydiatrofi.gr/wordpress/wp-includes/functions.php on line 6131wordpress-seo domain was triggered too early. This is usually an indicator for some code in the plugin or theme running too early. Translations should be loaded at the init action or later. Please see Debugging in WordPress for more information. (This message was added in version 6.7.0.) in /var/www/vhosts/mydiatrofi.gr/wordpress/wp-includes/functions.php on line 6131vw-nutritionist-coach ενεργοποιήθηκε πολύ νωρίς. Αυτό είναι συνήθως ένδειξη για κάποιο κώδικα στο πρόσθετο ή το θέμα που εκτελείται πολύ νωρίς. Οι μεταφράσεις θα πρέπει να φορτώνονται στην ενέργεια init ή αργότερα. Παρακαλώ δείτε τη σελίδα Debugging in WordPress για περισσότερες πληροφορίες. (Το μήνυμα αυτό προστέθηκε στην έκδ. 6.7.0.) in /var/www/vhosts/mydiatrofi.gr/wordpress/wp-includes/functions.php on line 6131vw-health-coaching ενεργοποιήθηκε πολύ νωρίς. Αυτό είναι συνήθως ένδειξη για κάποιο κώδικα στο πρόσθετο ή το θέμα που εκτελείται πολύ νωρίς. Οι μεταφράσεις θα πρέπει να φορτώνονται στην ενέργεια init ή αργότερα. Παρακαλώ δείτε τη σελίδα Debugging in WordPress για περισσότερες πληροφορίες. (Το μήνυμα αυτό προστέθηκε στην έκδ. 6.7.0.) in /var/www/vhosts/mydiatrofi.gr/wordpress/wp-includes/functions.php on line 6131
Διαγνωστική βρογχοσκόπηση.. ένα ταξίδι στα μονοπάτια του πνεύμονα

Σαρκοείδωση: Ένα επικίνδυνο αυτοάνοσο νόσημα

Ας δούμε ποιες τροφές καταστρέφουν τα δόντια μας!

Διατροφή.. Το ισχυρό όπλο για την αντιμετώπιση του HIV

Κόψτε το κάπνισμα και απολαύστε οφέλη

Καρκινική καχεξία.. Απειλή για τους ογκολογικούς ασθενείς

Διατροφή και πρόληψη του καρκίνου του προστάτη

Πώς θα απαλλαγείτε από τις πέτρες στα νεφρά!
Δίαιτα για την καταπολέμηση της Κάντιντα

McArdle.. μια σπάνια νόσος επηρεάζει τη μυϊκή λειτουργία